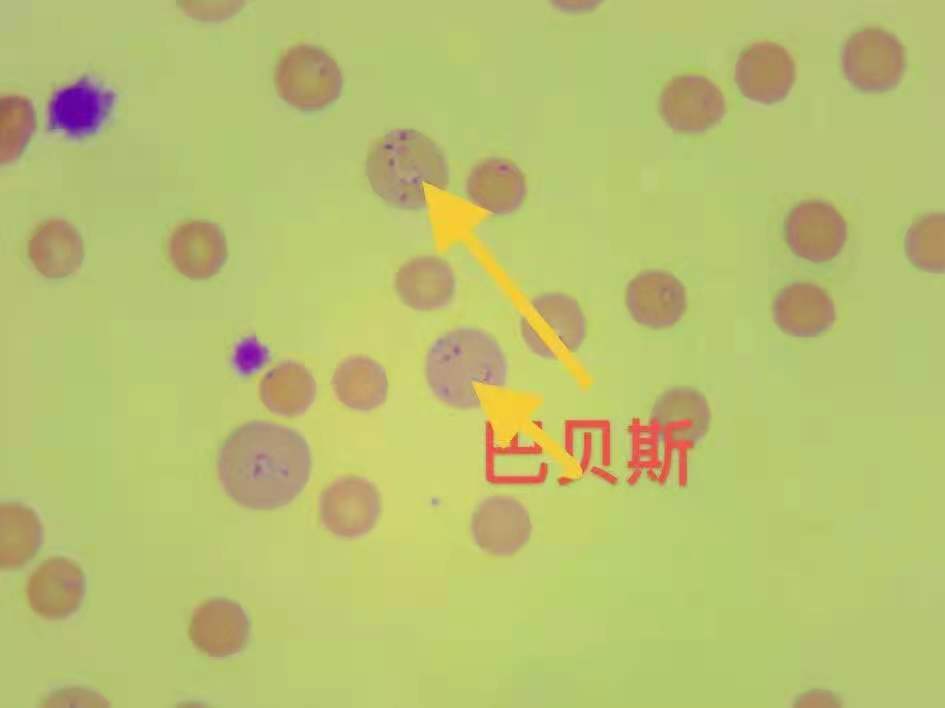

谷登社群小知识课堂开课啦
今天小谷带大家了解——巴布斯虫病
1、什么是巴布斯虫病

巴贝斯虫病是由巴贝斯虫引起的以【蜱虫】为媒介的血液寄生虫病。寄生于犬的巴贝斯虫主要有犬巴贝斯虫、吉氏巴贝斯虫和韦氏巴贝斯虫。
2、病原
(1)犬巴贝斯虫:寄生于犬红细胞内,典型虫体为梨形长约4-5μm,一端尖另一段圆,内有一个空泡,圆形或变形虫形虫体长为2-3μm,犬巴贝斯虫主要感染犬、狼、狐等犬科动物。
(2)吉氏巴贝斯虫:寄生于犬红细胞内,虫体形态呈圆形、环形、椭圆形、单梨形、杆形、偶尔见到十字形和成对梨形,多位于细胞边缘或偏中央,传播者为扇头蜱属和血蜱属的蜱。
(3)韦氏巴贝斯虫:虫体比犬巴贝斯虫稍大,呈圆形,卵圆形或梨形。
3、症状
(1)犬巴贝斯虫:自然感染犬潜伏期2-3周,实验性感染5-7天后体温升高常为39-40℃,有的在40℃以上,食欲减退,呕吐,尿呈黄褐色。
急性经过的犬,开始时体温40℃以上,并伴有黄疸性贫血,突然陷于虚脱。
慢性经过的犬,持续发热,出现贫血和轻度黄疸,肝和脾肿大,呈胆红素尿。
(2)吉氏巴贝斯虫:感染犬病初体温升高,持续3-5天后,有5-10天的体温正常期,呈不规则的回归热型。
患犬高度贫血,但常无黄疸发生,随着贫血加重,尿由黄至暗褐色。逐渐出现精神沉郁,食欲减退。
重症的明显营养不良,站立不稳,可视粘膜苍白。触诊脾脏明显肿大。有肝损害时,可视粘膜黄染。
(3)韦氏巴贝斯虫:常引起耳、背和其他部位皮肤的广泛性血,病犬常死于衰竭,如果耐过则于3-6周后贫血逐渐消失而康复。
4、诊断和治疗
出现症状需要去医院检查,根据医院检查血液图片中红细胞的虫体形态可以确诊。
确诊之后按照医生的建议治疗,遵医嘱。
5、防治措施
(1):对于巴贝斯虫预防的方法就是驱蜱虫,所以铲屎官需要定期对毛孩子体外驱虫(需选择具有驱蜱作用的体外驱虫药)。
(2):出去玩耍时尽量不要让狗狗在草丛和草坪趴过长的时间。
(3):对病犬应做到早发现,早诊断,早治疗。
(4):在疫区要做好犬体的防蜱灭蜱工作,可应用杀虫药,如25ppm溴氰菊酯溶液,每隔7~10天喷淋1次犬体
